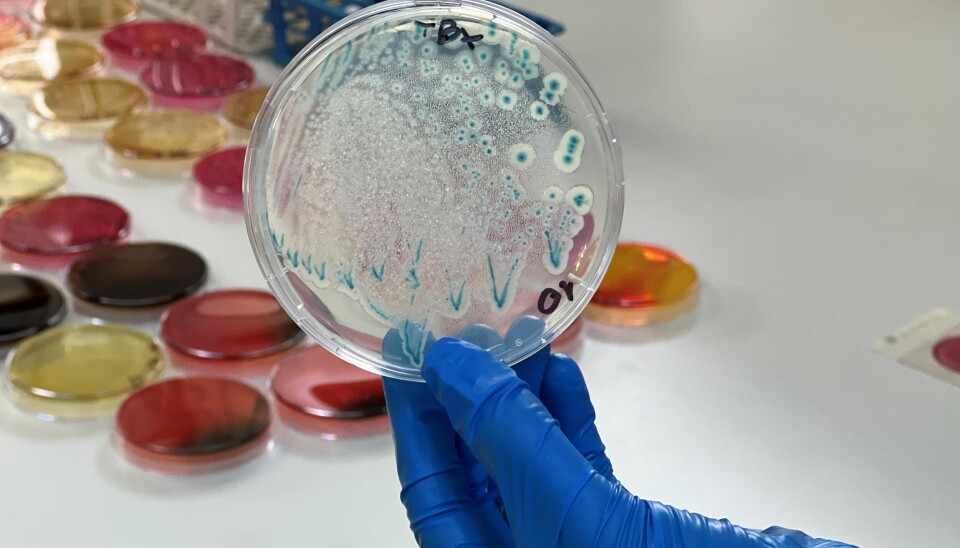
Favet crea Certificación de Calidad e Inocuidad de los Alimentos para fortalecer la acuicultura

Favet crea Certificación de Calidad e Inocuidad de los Alimentos para fortalecer la acuicultura
La Facultad de Ciencias Veterinarias y Pecuarias de la Universidad de Chile reafirma su compromiso con la inocuidad alimentaria y el fortalecimiento de la producción acuícola nacional.
Desde hace más de una década, Favet ha liderado programas de control oficial de residuos y contaminantes en alimentos de origen acuícola, prestando apoyo técnico al Servicio Nacional de Pesca y Acuicultura (Sernapesca) y generando evidencia científica clave para garantizar el cumplimiento de los estándares nacionales e internacionales de exportación.
A través de sus laboratorios acreditados: Inocuivet, de Inocuidad de los Alimentos, y Farmavet, de Farmacología Veterinaria, la facultad realiza análisis avanzados de residuos de antimicrobianos, metales pesados y otros contaminantes, asegurando que los productos del mar lleguen de forma segura a los consumidores chilenos y del mundo.
“Como universidad estatal, nuestra responsabilidad es generar capacidades que sirvan al país, asegurando que la acuicultura chilena crezca con una base sólida de confianza, trazabilidad y sostenibilidad”, señaló la Dra. Javiera Cornejo, Directora de Farmavet e Inocuivet.
Asimismo, la Dra. Cornejo destacó que “Favet se proyecta como un pilar técnico-científico para una acuicultura segura, sustentable y con reconocimiento internacional, al servicio de la salud pública y del desarrollo estratégico del país”.
Sernapesca, evaluando los sistemas de inocuidad de las empresas pesqueras, basados en el Análisis de Peligros y Puntos Críticos de Control (HACCP, por su sigla en inglés), realiza actualmente cerca de 100 auditorías al año con un equipo profesional altamente especializado, lo que contribuye a elevar los estándares de inocuidad en la industria.
Con el fin de adaptarse a los nuevos requisitos normativos y reafirmar la consistencia e imparcialidad del servicio de certificación que ofrece, Favet está implementando un sistema de gestión conforme a la norma ISO/IEC 17021-1:2015 “Evaluación de la conformidad. Requisitos para los organismos que realizan la auditoría y la certificación de sistemas de gestión”, la cual será acreditada para consolidarse como referente en la certificación de sistemas de calidad e inocuidad de los alimentos.
En este contexto, Favet ha impulsado el desarrollo de la Unidad de Certificación de Calidad e Inocuidad de los Alimentos, CERTIVET, que busca ofrecer herramientas objetivas para evaluar el cumplimiento de buenas prácticas en toda la cadena productiva. Esta entidad permitirá certificar sistemas de gestión en empresas acuícolas y agroalimentarias, consolidando el liderazgo técnico del sector público en la promoción de alimentos seguros.
“Con casi 30 años de experiencia en procesos de certificación, tenemos la certeza que CERTIVET será un socio estratégico para la industria. Estamos trabajando en un sistema que asegure que cada paso de los procesos de la cadena alimentaria, desde la producción hasta la comercialización, cumpla con los más altos estándares nacionales e internacionales. Así, mejoramos la competitividad de la industria productora de alimentos a nivel nacional, robusteciendo el potencial exportador del país”, sostuvo el Dr. José Manuel Yáñez, decano de Favet.
Como parte de su compromiso permanente con el sector, Favet extiende la invitación al seminario online “Desafíos de Inocuidad en Productos de la Pesca y Acuicultura”, que se realizará el próximo viernes 6 de junio a partir de las 11:00 horas (UTC-4); la instancia busca ser un espacio de diálogo y reflexión entre autoridades, especialistas y representantes de la industria sobre los retos regulatorios y tecnológicos que enfrenta.
La Dra. Alicia Gallardo es la principal expositora de este encuentro y señaló que “en un mundo cambiante, donde debemos estar preparados y tener resiliencia, en especial frente a la inocuidad de los alimentos que es muy importante para alimentar al mundo, con proteína de buena calidad, como la proteína de la pesca y la acuicultura es importante tener este tipo de seminarios en que se abordan con un enfoque de riesgos, tomando en consideración los aspectos de Una Salud, como prepararnos para abordar estos riesgos y como tener una postura adelantada y compartirlos desde el punto de vista científico y regulatorio”.